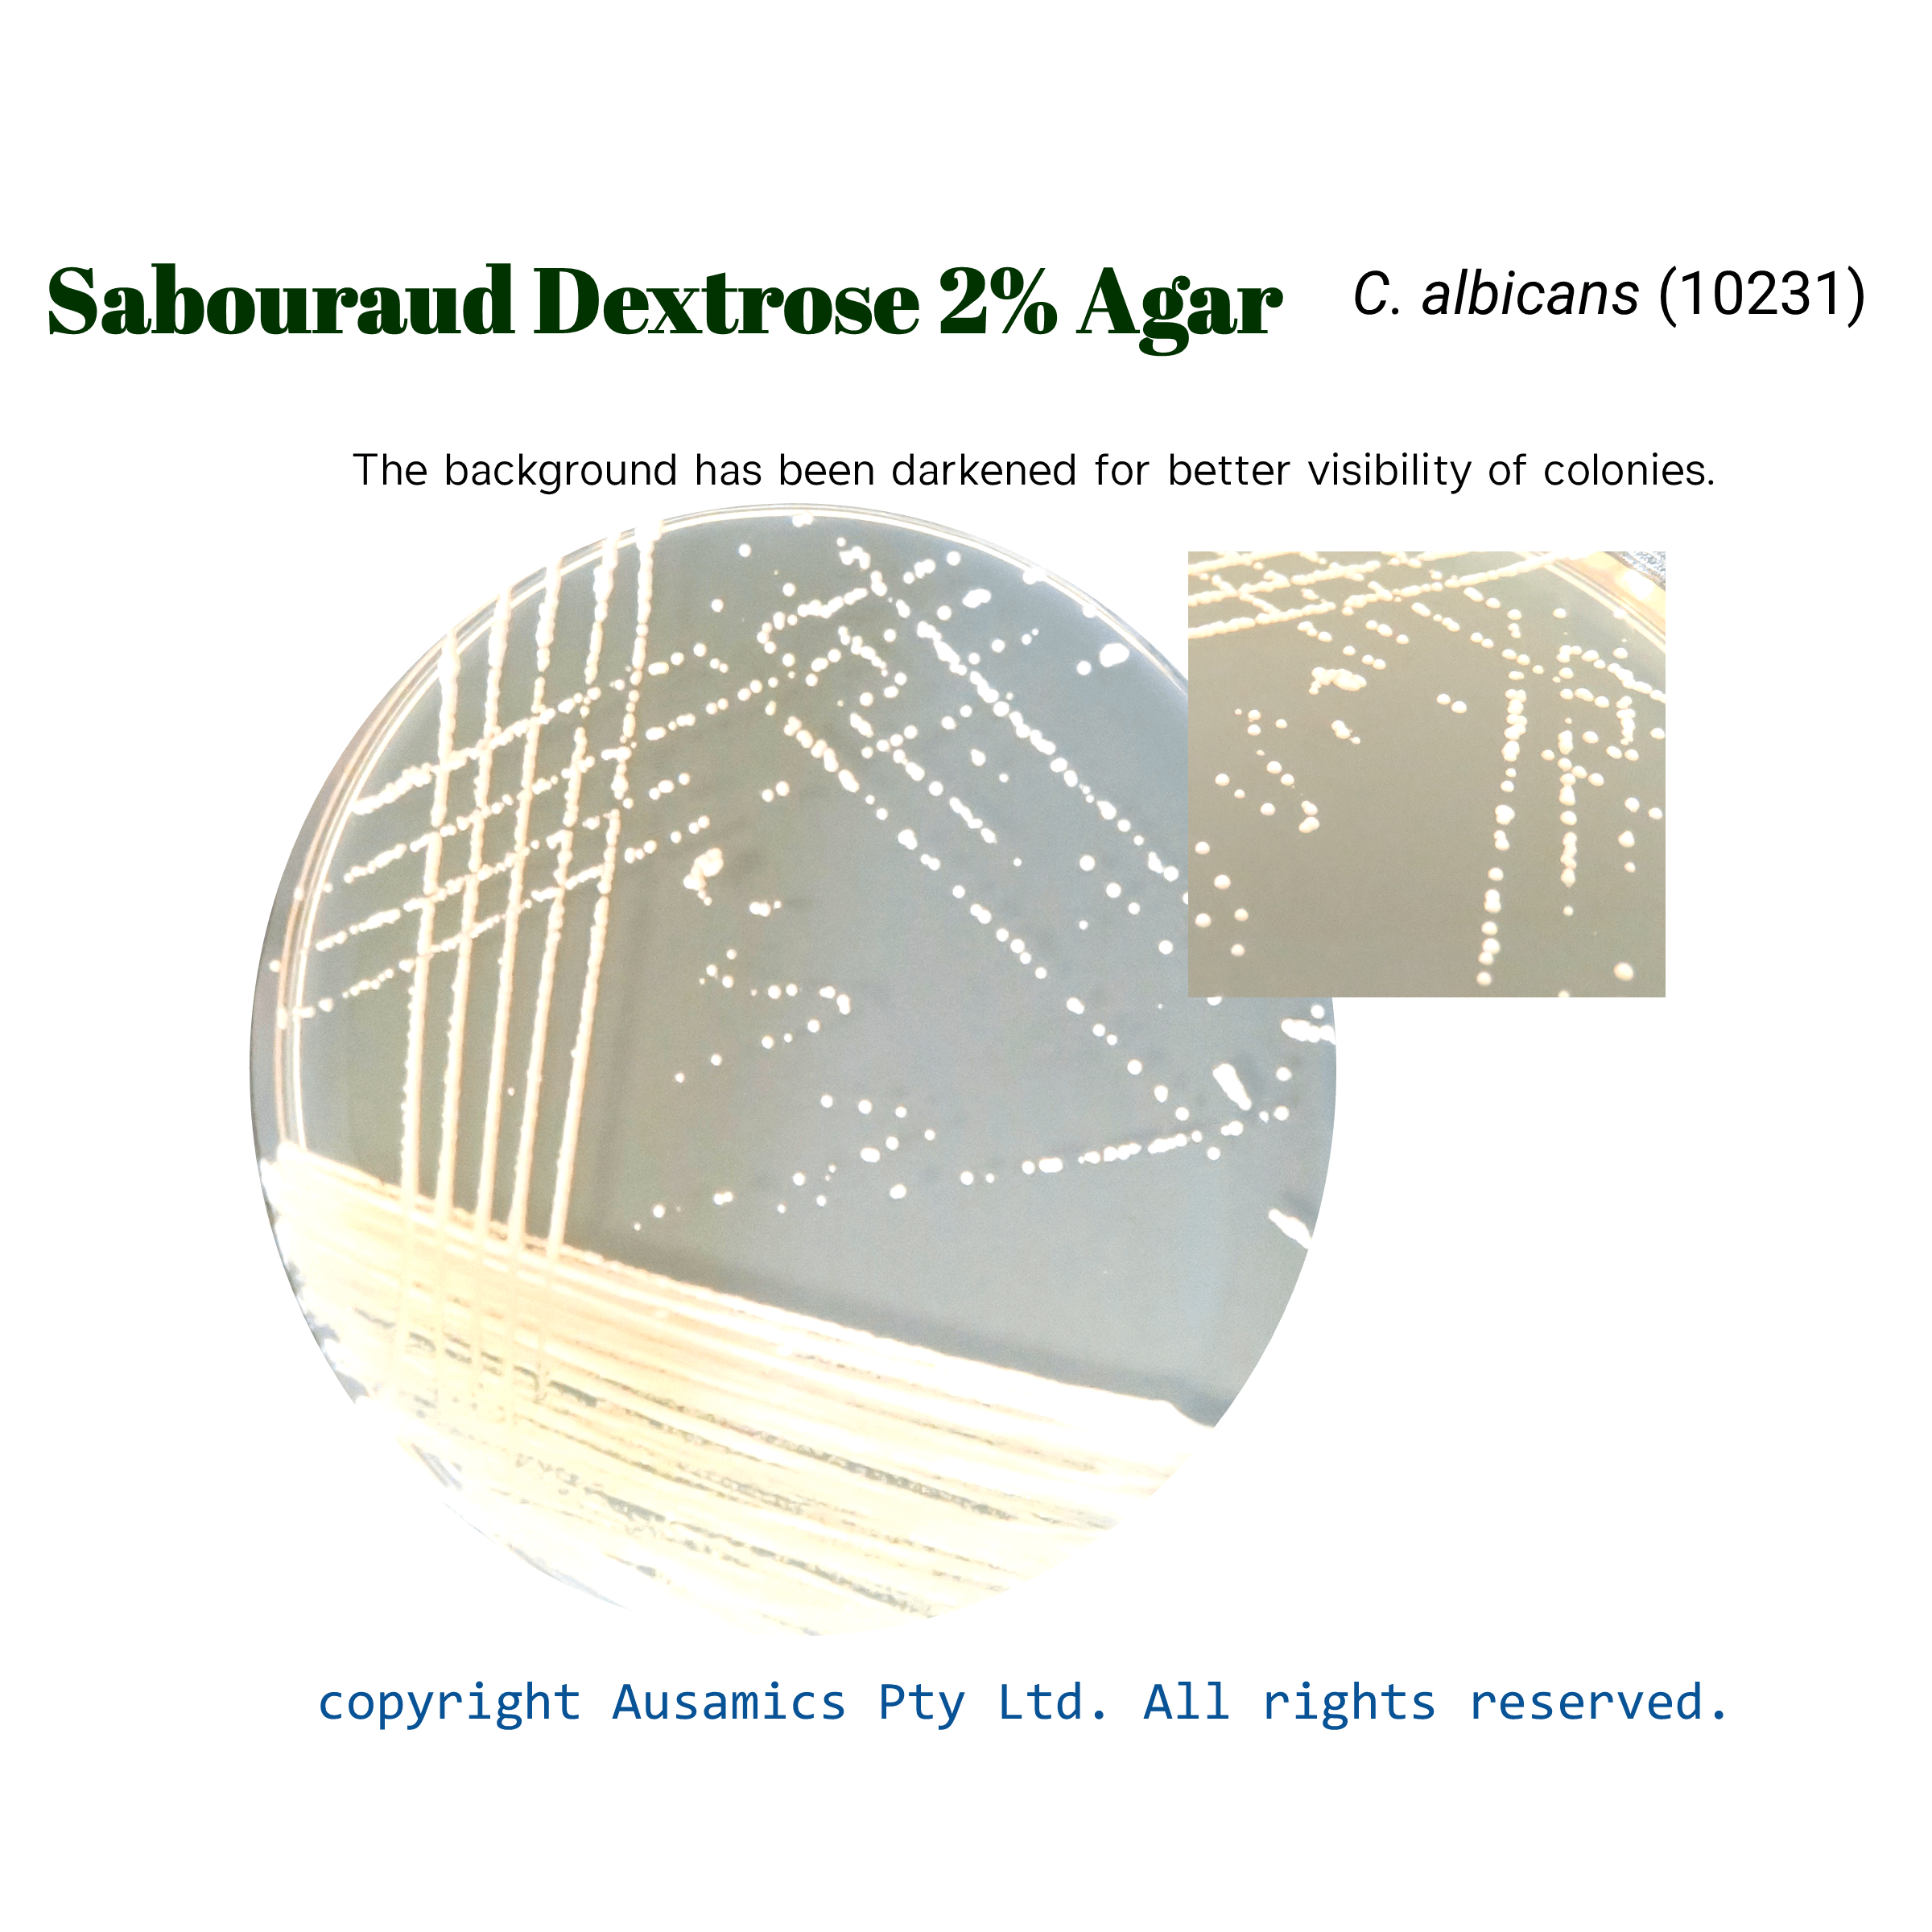
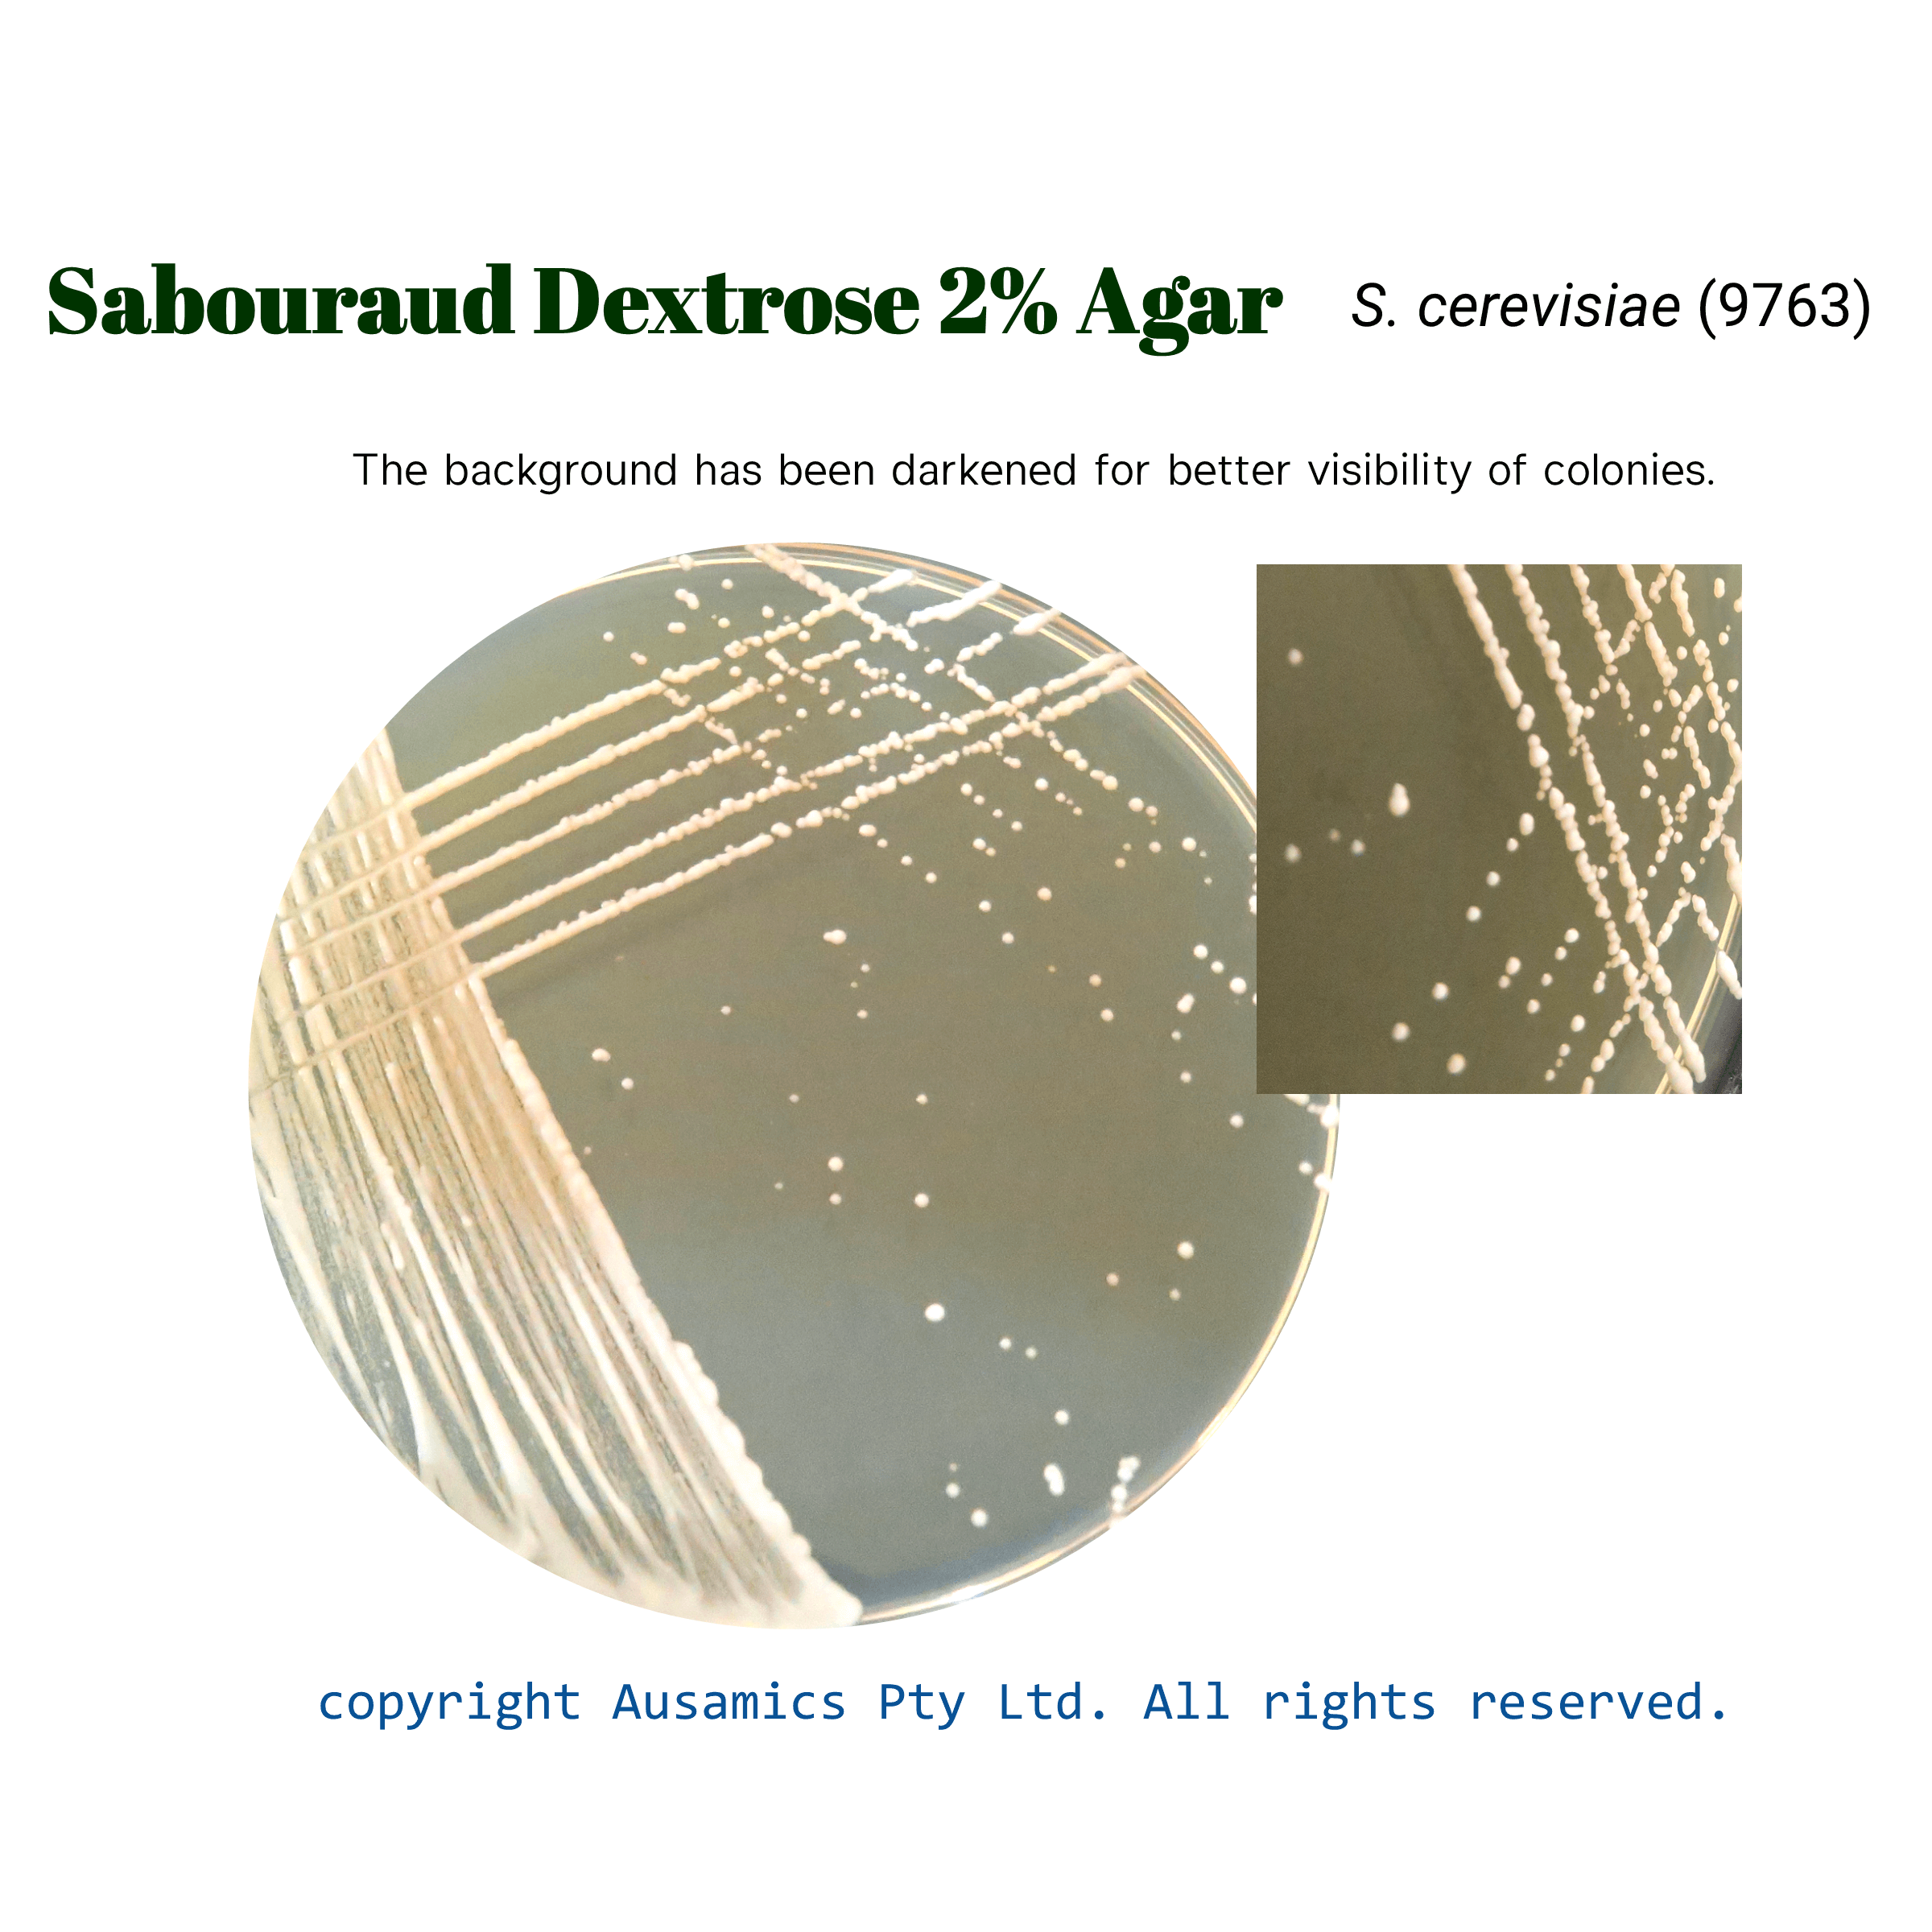

Sabouraud Dextrose Agar, SDA
Used in qualitative procedures for cultivation of pathogenic and nonpathogenic fungi, particularly dermatophytes.
- Description
- Composition
- Quality Control
- Microbial Test Results
The versatile Sabouraud Dextrose Agar (SDA) medium is used to cultivate yeasts, molds, and to test for the absence of Candida albicans. Because of its special formulation, which has a low pH and a high dextrose content, yeasts and molds can thrive there easily. This media facilitates not just their growth but also the production of pigments and spores. Crucially, Sabouraud Dextrose Agar successfully stops the growth of bacteria.
Yeasts and molds are two subtypes of fungi, which were among the first microorganisms to be identified owing to their obvious fruiting structures, like mushrooms. Fungal illnesses that affect the skin, hair, and mucous membranes are caused by dermatophytes. It’s crucial to choose a medium for fungal isolation that promotes fungal growth while inhibiting bacterial development.
Sabouraud Dextrose Agar is frequently used for microbiological limit tests in the food, cosmetic, and pharmaceutical industries and complies with international standards. Peptones and dextrose, two of the medium’s constituents, supply the nutrients required for fungal development while keeping the pH low enough to inhibit bacterial contamination. It is advisable to take safety precautions, particularly while handling potentially airborne infectious fungus spores. Inhibitory substances can be applied to samples that are highly polluted to stop the growth of bacteria. Any white colonies that are seen could be a sign that Candida albicans is present.
Storage
Keep the container at 15-30 °C and prepared medium at 2-8 °C.
| Composition | (gr/L) |
| Pancreatic Digest of Casein | 5 |
| Peptic Digest od Animal Tissue | 5 |
| Dextrose | 40 |
| Agar | 15 |
| Final pH at 25°C | 5.6 ± 0.2 |
| Dehydrated Appearance | Light beige, free-flowing, homogeneous. |
| Prepared Appearance | Light to medium amber, slightly opalescent. |
| Reaction of 6.5% Solution at 25°C | pH 5.6 ± 0.2 |
| Prepare the medium per label directions. Inoculate and incubate at 30± 2°C for 18-48 hours, or up to 7 days for Trichophyton. Incubate (*) cultures at 20-25°C for up to 5 days. Incubate (**) culture at 30-35°C for 48 hours. | |
| Organism (ATCC) | Recovery |
| Saccharomyces cerevisiae (9763) | Good |
| Aspergillus brasiliensis (niger)* (16404) | Good |
| Candida albicans* (10231) | Good |
| Candida albicans** (10231) | Good |